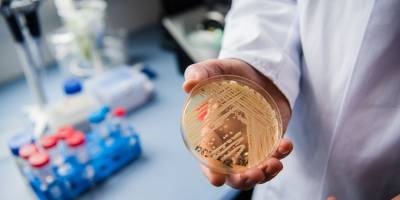
Candida auris mantarıyla yapay zeka desteği ile mücadele edilecek

- “Sadece mutlu bir azınlığa hizmet ediyorsunuz”
- “Ekonomi Bakanlığı bizler için yok”
- “Ekonomi yönetimi iflas etti, tasarruf da yok enflasyonla mücadele de”
- “İnsanların parası var ki güneye geçip alışveriş yaparlar”
- “Enflasyon sepeti ihalesinde bile yolsuzluk kokusu var”
- “Çocuklarımıza borcumuzu ödemek için ciddiyetle, hep birlikte, çok çalışmakla yükümlüyüz”
- Geçitkale-Serdarlı Belediyesi mandıralarda kapsamlı önlem başlattı
- “Ekonomide temel hedef, ülke gelirlerini artırmak olmalıdır”
- Kıymalı Tart Tarifi
- Canbulat Özgürlük Ortaokulu’nun “su tasarrufu” temalı resim sergisi Gazimağusa Belediyesi’nin zemin katında açıldı